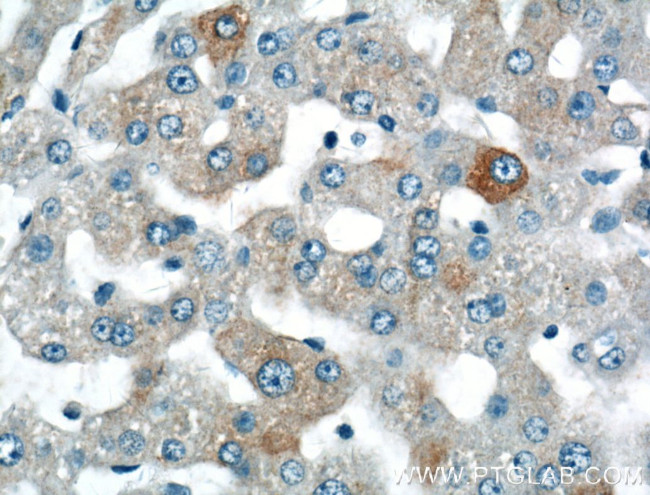
SPG11 Antibody in Immunohistochemistry (Paraffin) (IHC (P))

Search
Proteintech
SPG11 Polyclonal Antibody
{{$productOrderCtrl.translations['antibody.pdp.commerceCard.promotion.promotions']}}
{{$productOrderCtrl.translations['antibody.pdp.commerceCard.promotion.viewpromo']}}
{{$productOrderCtrl.translations['antibody.pdp.commerceCard.promotion.promocode']}}: {{promo.promoCode}} {{promo.promoTitle}} {{promo.promoDescription}}. {{$productOrderCtrl.translations['antibody.pdp.commerceCard.promotion.learnmore']}}
产品信息
16555-1-AP
种属反应
已发表种属
宿主/亚型
分类
类型
抗原
偶联物
形式
浓度
规格
纯化类型
保存液
内含物
保存条件
运输条件
产品详细信息
Immunogen sequence: TLVGMKLLD KISSVPHGEL SCTTELLILA HHCFTLTCHM EGIIRVLQAA HMLTDNHLAP SEEYGLVVRL LTGIGRYNEM TYIFDLLHKK HYFEVLMRKK LDPSGTLKTA LLDYIKRCRP GDSEKHNMIA LCFSMCREIG ENHEAAARIQ LKLIESQPWE DSLKDGHQLK QLLLKALTLM LDAAESYAKD SCVRQAQHCQ RLTKLITLQI HFLNTGQNTM LINLGRHKLM DCILALPRFY QASIVAEAYD FVPDWAEILY QQVILKGDFN YLEEFKQQRL LKSSIFEEIS KKYKQHQPTD MVMENLKKLL TYCEDVYLYY KLAYEHKFYE IVNVLLKDPQ TGCCLKDMLA G (133-482 aa encoded by BC024161)
靶标信息
Hereditary spastic paraplegias (HSPs) are genetically and phenotypically heterogeneous disorders. Spastic paraplegia with thinning of the corpus callosum (ARHSP-TCC) is a relatively frequent form of complicated hereditary spastic paraplegia (cHSP) in which mental retardation and muscle stiffness at onset are followed by slowly progressive paraparesis and cognitive deterioration. Mutations of the SPG11 gene encoding the spatacsin protein have been identified as a major cause of HSP-TCC. Spatacsin is a potential transmembrane protein that is phosphorylated upon DNA damage. It is expressed in all structures of the brain, with a high expression in the cerebellum. SPG11 mutations may occur more frequently in familial than sporadic forms of cHSP without TCC. Kjellin syndrome is found to be associated with mutations in not only the SPG15 gene but also SPG11 gene. Recent studies show Parkinsonism may initiate SPG11-linked HSP TCC and that SPG11 may cause juvenile Parkinsonism.
仅用于科研。不用于诊断过程。未经明确授权不得转售。
生物信息学
蛋白别名: amyotrophic lateral sclerosis 5; Colorectal carcinoma-associated protein; spastic paraplegia 11 (autosomal recessive); Spastic paraplegia 11 protein; Spastic paraplegia 11 protein homolog; Spatacsin; SPG11, spatacsin vesicle trafficking associated; unnamed protein product
基因别名: 6030465E24Rik; A330015I11; ALS5; C530005A01Rik; CMT2X; KIAA1840; RGD1562529; SPG11
UniProt ID: (Human) Q96JI7, (Mouse) Q3UHA3
Entrez Gene ID: (Human) 80208, (Mouse) 214585, (Rat) 311372